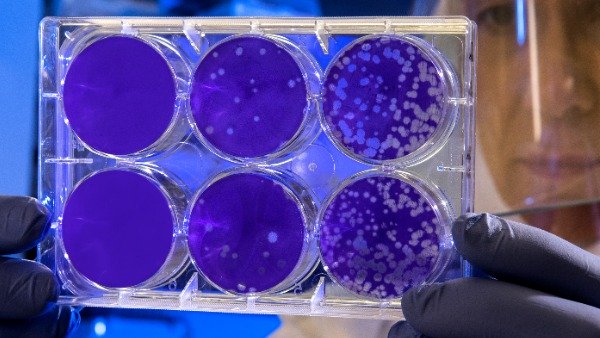

The Department of Biotechnology has launched a ‘One Health’ consortium that envisages carrying out surveillance of important bacterial, viral and parasitic infections of zoonotic as well as transboundary pathogens in the country. The project also looks into the use of existing
http://dlvr.it/S9byPw